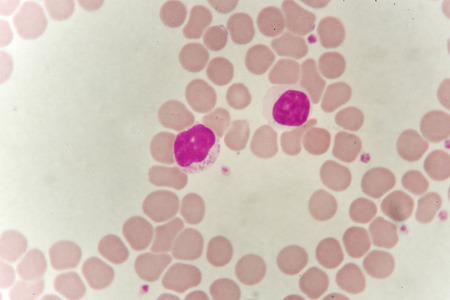
Lymphocyte cell in blood smearの写真素材

写真素材 - Lymphocyte cell in blood smear
キーワード
- Neutrophil
- abnormal
- analyzing
- anemia
- basophil
- blood sample
- blood smear
- blood test
- checkup
- disease
- eosinophil
- erythrocyte
- examination
- health care
- hematology
- hematopoiesis
- hemophilia
- laboratory
- leukemia
- leukocyte
- lymphocyte
- medical exam
- medical technology
- medical test
- microscope
- microscopic cells
- microscopy
- monocyte
- pathology
- platelet
- red blood cell
- research
- science
- thalassemia
- thrombocyte
- white blood cell
類似作品
Malaria blood p...
Immature white...
Blast cells in ...
Picture of acut...
Blood smear of ...
Microscopic vie...
Malaria blood p...
neutrophils. bl...
A blood smear i...
Human blood sme...
Blood cancer.bl...
nucleated red c...
Neutrophil show...
Promyelocye
White blood cel...
Lymphocyte cell...
Human blood sme...
Neutrophil cell...
Comparison whit...
White blood cel...
Blood smear wit...
plasma cell hum...
Immature cells ...
Acute promyeloc...
Leukemia cells
Blood smear sh...
Blurred test tu...
Picture of acut...
Immature and ma...
A blood smear i...
A blood smear i...
Picture of acut...
neutrophil
White blood cel...
Blood smear
in Slide blood ...
Neutrophil cell
complete blood ...
Lymphocyte cell...
Neutrophil with...
Blood smear sh...
complete blood ...
Microscopically...
Blood smear wit...
blood smear is ...
Leukemia cells
in slide blood ...
Multinucleated ...
Red blood cells...